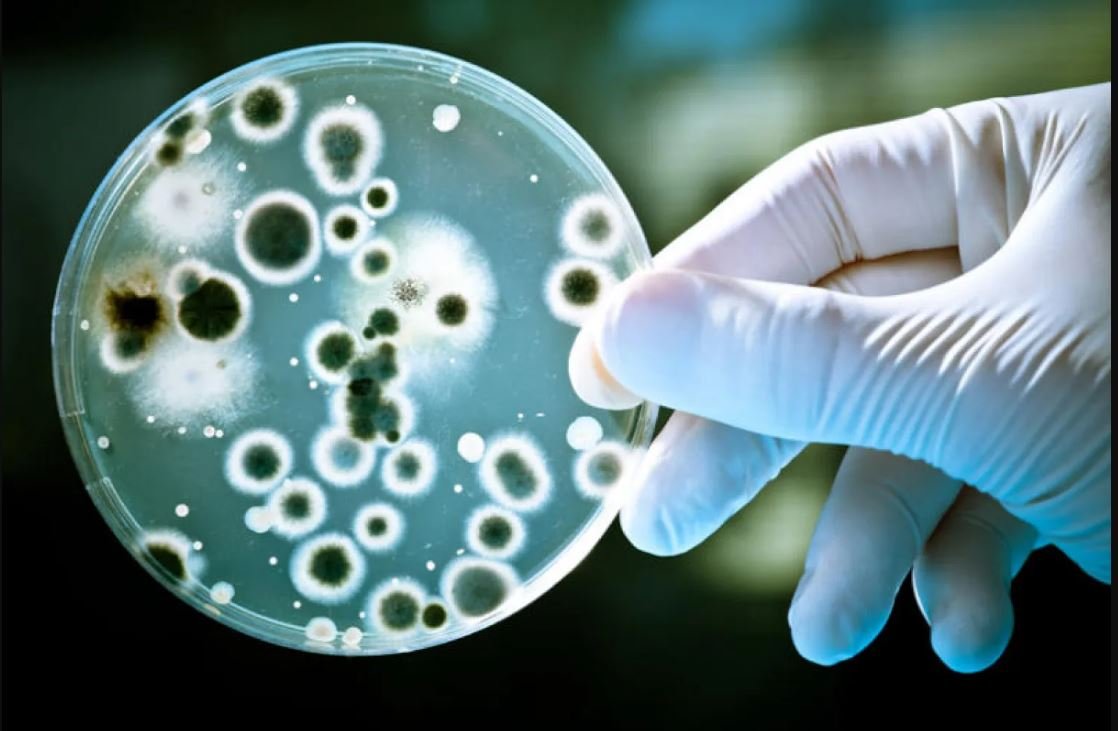
البكتيريا

دراسة علمية تكشف آليتين مختلفتين لبقاء البكتيريا رغم المضادات الحيوية

كشفت دراسة علمية حديثة عن آليات غير متوقعة تمكّن البكتيريا من النجاة من تأثير المضادات الحيوية، موضحة أن البقاء لا يقتصر فقط على الدخول في حالة “سبات” كما كان شائعًا في الأوساط العلمية، بل يعتمد على وضعين مختلفين تمامًا للبقاء على قيد الحياة.
الدراسة، التي نُشرت في دورية “ساينس أدفانسيس” (Science Advances)، تسلط الضوء على تفسير جديد لظاهرة تُعرف باسم ثبات البكتيريا أمام المضادات الحيوية، وهي من أبرز الأسباب وراء فشل علاج بعض العدوى وعودة الالتهابات بعد تحسنها مؤقتًا.

لماذا تنجو بعض البكتيريا من المضادات الحيوية؟
في العادة، تعمل المضادات الحيوية على قتل البكتيريا الضارة أو منعها من التكاثر. لكن في بعض الحالات، وخاصة في العدوى المزمنة أو المستعصية، ينجو عدد ضئيل من الخلايا البكتيرية، ليعود لاحقًا ويتسبب في انتكاسات متكررة.
وكان الاعتقاد السائد بين العلماء أن هذه الخلايا الباقية تدخل ببساطة في حالة سبات مؤقت، توقف فيها نشاطها الحيوي، ما يجعلها غير قابلة للتأثر بالأدوية. غير أن البحث الجديد يكشف أن الصورة أكثر تعقيدًا.
وضعان مختلفان لبقاء البكتيريا
توصل فريق البحث إلى أن البكتيريا تعتمد على مسارين رئيسيين للبقاء عند التعرض للمضادات الحيوية:
أولًا: التوقف المنظم للنمو (السبات المحمي)
في هذا الوضع، تدخل البكتيريا حالة مدروسة من التباطؤ الشديد في النشاط الحيوي، أشبه بالسبات.
تقوم الخلايا عمدًا بإبطاء عملياتها الأيضية والانقسام، ما يجعل المضادات الحيوية – التي تستهدف عادة الخلايا النشطة – أقل فاعلية في القضاء عليها.
هذا النمط كان معروفًا جزئيًا في السابق، ويُعد أحد أسباب استمرار بعضها في الجسم رغم العلاج.

ثانيًا: التوقف المضطرب للنمو (الحالة غير المستقرة)
أما الاكتشاف الأهم في الدراسة، فهو تحديد وضع جديد تمامًا، لا تدخل فيه سباتًا منظمًا، بل تفقد السيطرة على وظائفها الحيوية الأساسية.
في هذه الحالة:
تعاني البكتيريا من اضطراب شديد في نشاطها الداخلي
يضعف استقرار غشاء الخلية
تصبح الخلايا أقل توازنًا وأكثر هشاشة
ويرى الباحثون أن هذه الحالة تمثل نقطة ضعف يمكن استغلالها علاجيًا، إذ قد تصبح البكتيريا أكثر قابلية للاستهداف بوسائل دوائية جديدة.
تفسير نتائج علمية متضاربة
وقالت البروفيسورة ناتالي بالابان من الجامعة العبرية، المشرفة على الدراسة، إن هذا الاكتشاف يفسر سنوات طويلة من النتائج العلمية المتناقضة حول كيفية بقاء البكتيريا بعد العلاج بالمضادات الحيوية.
وأضافت:
“التمييز بين المسارين المختلفين للبقاء يفتح آفاقًا جديدة لفهم العدوى البكتيرية، ويوفر فرصًا حقيقية لتطوير علاجات أكثر دقة وفعالية”.
أدوات متقدمة لرصد خلية واحدة
قاد الدراسة الطالب الباحث أدي روتيم، الذي اعتمد مع الفريق البحثي على مزيج متقدم من الأدوات العلمية، شمل:
نمذجة رياضية عالية الدقة
قياس التعبير الجيني للبكتيريا
تتبع التغيرات الأيضية باستخدام مجسات حرارية فائقة الحساسية
تقنيات الميكروفلويديك لمراقبة سلوك خلية بكتيرية واحدة في ظروف محكمة
هذه التقنيات سمحت للباحثين بالتمييز بدقة بين البكتيريا التي دخلت في توقف منظم، وتلك التي وقعت في توقف مضطرب، وهو ما لم يكن ممكنًا في الدراسات السابقة.
انعكاسات خطيرة على علاج العدوى
يساهم ثبات البكتيريا أمام المضادات الحيوية في تفاقم مشكلات صحية واسعة النطاق، من بينها:
التهابات المسالك البولية المتكررة
العدوى المرتبطة بالأجهزة الطبية المزروعة
الالتهابات المزمنة التي تفشل في الاستجابة للعلاج التقليدي
وتشير الدراسة إلى أن عدم التمييز بين نوعي البقاء البكتيري قد يكون أحد أسباب فشل العلاج الحالي.
اقرأ أيضًا:
سلالة الإنفلونزا «كيه» تثير اهتمام العلماء| ماذا نعرف عن المتحور الجديد من H3N2؟
نحو علاجات مخصصة وأكثر فاعلية
يؤكد الباحثون أن فهم الفروق بين آليات البقاء المختلفة قد يمهد الطريق لتطوير علاجات مخصصة تستهدف كل نوع من الخلايا البكتيرية المستمرة على حدة.
وقال فريق البحث في ختام الدراسة:
“هناك أكثر من طريقة تمكّن البكتيريا من النجاة رغم المضادات الحيوية، وفهم هذه الاختلافات قد يغير جذريًا الطريقة التي نعالج بها العدوى في المستقبل”.






